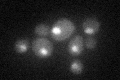
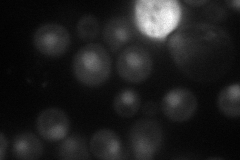
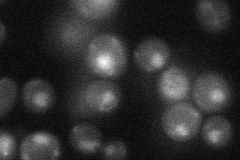

View description
Subunit of COMPASS (Set1C), a complex which methylates histone H3 on lysine 4 and is required in telomeric transcriptional silencing; interacts with Orc2p; PHD finger domain protein similar to human CGBP, an unmethylated CpG binding protein
Localization:
Intensity:
Fold change:
Significance:
-
C’ GFP library in SD
nucleus25.34 -
N' NOP1pr-GFP in SD
nucleus47.3674 -
N' TEF2pr-mCherry in SD

nucleus63.2472 -
N' NATIVEpr-GFP in SD
nucleus26.8419 -
N' TEF2pr-VC and Cyto-VN in SD

#N/A0 -
C’ GFP library in SD+DTT

nucleus22.750.89No -
C’ GFP library in SD+H2O2

nucleus25.821.01No -
C’ GFP library in Starvation Media

nucleus30.971.22No -
C’ GFP library on the background of Pup2-DaMP

nucleus -
C’ GFP library on the background of CCT mutant

nucleus24.43890.96416No
